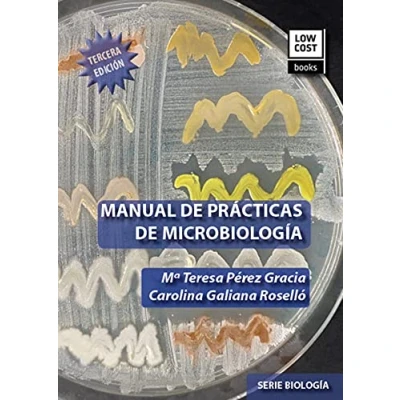

MANUAL DE PRACTICAS MICROBIOLOGIA. 3RA.EDICION
Precios a partir de
COMPARAR TODAS LAS TIENDAS WEB
(3)
Amazon
Páginas: 164, Edición: Third, Impresión por encargo (tapa blanda), Psylicom Ediciones (PA)
Leer más
19,00
Destacado

|
19,00 € |
Ver oferta
|

|
20,69 € |
Ver oferta
|

|
20,69 € |
Ver oferta
|
 Descripción
Descripción
Amazon
Páginas: 164, Edición: Third, Impresión por encargo (tapa blanda), Psylicom Ediciones (PA)
Comparar tiendas web (3)
Shop


Precio


Precios actualizados por última vez el:

Especificaciones del producto
Especificaciones del producto




